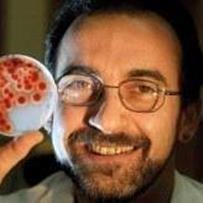
Profile picture

Alex Andrianopoulos
Doctorate
-
The University of MelbourneParkville, Australia
